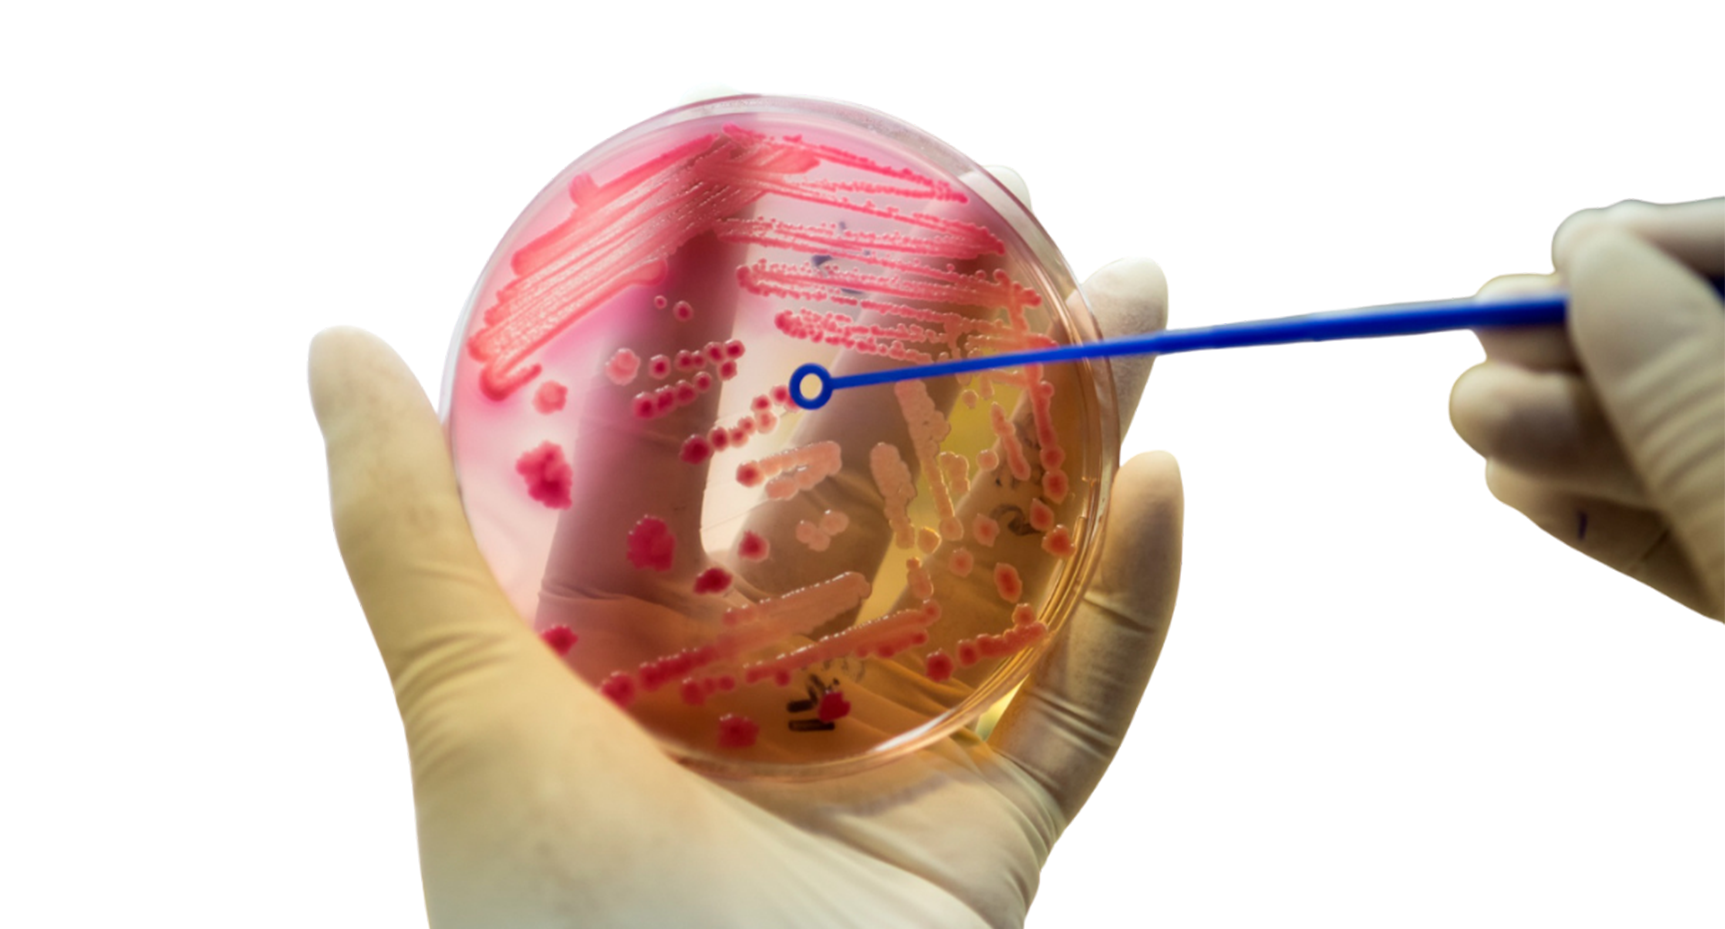
Advanced Treatment Icon

What Is Blastocyst Culture?
At Queens IVF, we believe that precision, advanced science, and personalized fertility care together create the best chance for a successful pregnancy. One of the most advanced techniques we offer is blastocyst culture and transfer. This proven IVF method helps improve implantation rates and overall treatment outcomes for many patients struggling with infertility. Blastocyst culture is an advanced IVF laboratory process in which fertilized embryos are cultured for 5 to 6 days instead of the traditional 2 to 3 days. During this time, embryos grow from early cleavage stages into blastocysts, which are more developed and closely resemble the stage at which implantation naturally occurs in the uterus.
Initial Consultation and Medical Review Blastocyst culture and transfer begins with a detailed consultation to review the couple’s medical history, previous fertility treatments, and reproductive concerns. Specialists assess test results, ovarian reserve reports, and prior cycles to determine suitability for the procedure. This evaluation ensures that the treatment plan is personalized and tailored to maximize success.
Prior to the procedure, mature eggs and sperm are carefully examined. Women undergo ovarian stimulation and monitoring via ultrasounds and hormonal tests, while sperm quality is analyzed to select the healthiest and most motile cells. Accurate assessment ensures only the best eggs and sperm are used for fertilization.
Retrieved eggs are fertilized in the laboratory using IVF or ICSI techniques. Fertilized embryos are then cultured in a controlled environment for 5–6 days until they reach the blastocyst stage. Extended culture allows embryologists to select the most viable embryos for transfer, improving implantation potential.
Once healthy blastocysts are identified, they are carefully transferred into the uterus using a minimally invasive procedure. The timing and placement are optimized to enhance implantation chances. Hormonal support is provided to create an ideal uterine environment for the developing embryo.
After the transfer, patients receive ongoing medical guidance, hormonal therapy, and follow-up evaluations. Pregnancy tests are conducted at the appropriate time, and results are reviewed to plan the next steps if needed. Queen’s IVF provides expert care throughout the blastocyst culture and transfer process, ensuring a safe and effective fertility journey.
Initial Consultation and Medical Review Blastocyst culture and transfer begins with a detailed consultation to review the couple’s medical history, previous fertility treatments, and reproductive concerns. Specialists assess test results, ovarian reserve reports, and prior cycles to determine suitability for the procedure. This evaluation ensures that the treatment plan is personalized and tailored to maximize success.

Extended culture to the blastocyst stage helps identify the healthiest embryos for transfer, increasing the likelihood of successful pregnancy.

Blastocyst transfer is recommended for patients looking to enhance implantation potential and improve overall IVF success rates.

Blastocyst culture enables confident single embryo transfers, reducing the risk of multiple pregnancies while maintaining high success rates.
Find quick answers, or reach out to our support team for more help.
© 2026 All rights reserved by Queens IVF Clinic